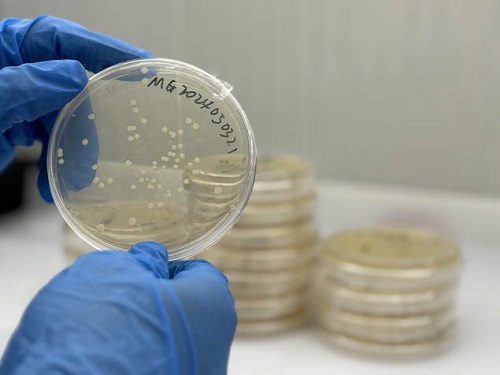
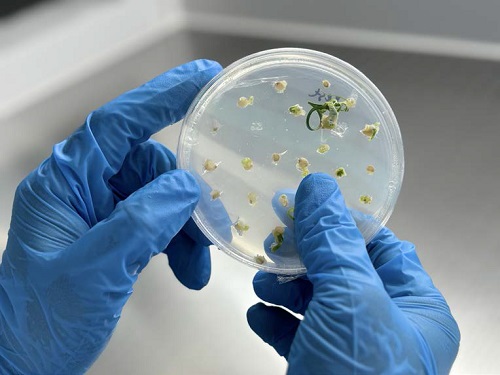

Degradation
of Germplasm Resources
Currently, the issue of germplasm degradation is increasingly drawing widespread attention. Germplasm resources serve as a crucial foundation for agricultural production. However, due to various factors, the germplasm resources of many crops and organisms are undergoing severe degradation. This degradation manifests in several aspects, including reduced genetic diversity, decreased stress resistance, and declining productivity.